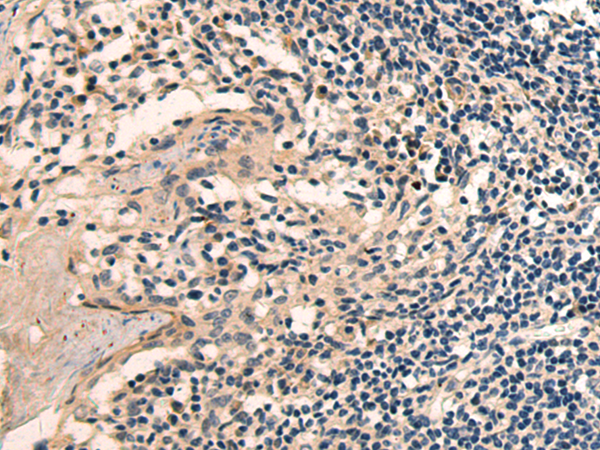

中文名称: 兔抗SEMA3C多克隆抗体
英文名称:Anti-SEMA3C rabbit polyclonal antibody
别 名:semaphorin 3C; SemE; SEMAE
相关类别:一抗
储 存:冷冻(-20℃)
宿 主:Rabbit
抗 原:SEMA3C
反应种属:Human, Mouse
标 记 物:Unconjugate
克隆类型:rabbit polyclonal
技术规格
|
Background:
|
This gene encodes a secreted glycoprotein that belongs to the semaphorin class 3 family of neuronal guidance cues. The encoded protein contains an N-terminal sema domain, integrin and immunoglobulin-like domains, and a C-terminal basic domain. Homodimerization and proteolytic cleavage of the C-terminal propeptide are necessary for the function of the encoded protein. It binds a neuropilin co-receptor before forming a heterotrimeric complex with an associated plexin. An increase in the expression of this gene correlates with an increase in cancer cell invasion and adhesion. Naturally occurring mutations in this gene are associated with Hirschsprung disease.
|
|
Applications:
|
ELISA, IHC
|
|
Name of antibody:
|
SEMA3C
|
|
Immunogen:
|
Fusion protein of human SEMA3C
|
|
Full name:
|
semaphorin 3C
|
|
Synonyms:
|
SemE; SEMAE
|
|
SwissProt:
|
Q99985
|
|
ELISA Recommended dilution:
|
5000-10000
|
|
IHC positive control:
|
Human tonsil
|
|
IHC Recommend dilution:
|
50-100
|
酶联生物经过不断的实验优化和改进,积累了大量的经验,拥有专业的酶联研发团队。利用专业的酶联免疫技术自主研发的elisa试剂盒,能对血清及其它样本定量检测抗原,定性检测特异性抗体。优质的试剂,先进的仪器和正确的操作是保证ELISA检测结果准确可靠的必要条件。ELISA检测的方便性、稳定性、重复性和可靠性方面都具有很大的优势。
ELISA检测技术服务内容:
1、双抗体夹心法检测抗原 2、间接法检测抗体 3、为客户提供各种ELISA技术进行样本检测。

以上代测费,凡购买本公司试剂盒,我们免费代测!
凡购买本公司目录任何一种酶联免疫检测试剂盒,您只需将需要检测的动物(Human, Rat, Mouse, Rabbit, Monkey,
Pig……)种类和检测指标(白介素类、激素类)及标本数量(48T/96T)通知公司业务员即可。在接到客户标本当日起,现货产品一周内将检测报告交到客户手中!
欢迎各科研单位在各种项目上与我们公司开展不同层次的密切合作,以双赢求发展,共同进步,为中国检测事业的发展积累经验。
二、样本要求
在收集标本前都必须有一个完整的计划,必须清楚要检测的成份是否足够稳定。我们提倡新鲜标本尽早检测,对收集后当天就进行检测的标本,及时储存在4℃备用,如有特殊原因需要周期收集标本,请造模取材后,将标本及时分装后放在-20℃或-70℃条件下保存。因冰室与室温存在一定温差,蛋白极易降解,直接影响实验质量,所以避免反复冻融。代测放免标本的客户取材前须向我司销售人员索要说明书,具体操作注意事项请与我司技术人员沟通。
液体类标本:标本必须为液体,不含沉淀。包括血清、血浆、尿液、胸腹水、脑脊液、细胞培养上清、组织匀浆等。
血清:室温血液自然凝固10-20分钟后,离心20分钟左右(2000-3000转/分)。收集上清。如有沉淀形成,应再次离心。
血浆:应根据试剂盒的要求选择EDTA、柠檬酸钠或肝素作为抗凝剂,加入10%(v/v)抗凝剂(0.1M柠檬酸钠或1%heparin
或2.0%EDTA.Na2)混合10-20分钟后,离心20分钟左右(2000-3000转/分)。仔细收集上清。如有沉淀形成,应再次离心。
尿液、胸腹水、脑脊液:用无菌管收集。离心20分钟左右(2000-3000转/分)。仔细收集上清。如有沉淀形成,应再次离心。
细胞培养上清:检测分泌性的成份时,用无菌管收集。离心20分钟左右(2000-3000转/分)。仔细收集上清。检测细胞内的成份时,用PBS(PH7.0-7.4)稀释细胞悬液,细胞浓度达到100万/ml左右。通过反复冻融,以使细胞破坏并放出细胞内成份。离心20分钟左右(2000-3000转/分)。仔细收集上清。保存过程中如有沉淀形成,应再次离心。
组织标本:切割标本后,称取重量。加入一定量的PBS,缓冲液中可加入1μg/L蛋白酶抑制剂或50U/ml的Aprotinin(抑肽酶)。用手工或匀浆器将标本匀浆充分。离心20分钟左右(2000-3000转/分)。仔细收集上清置于-20度或-70度保存,如有必要,可以将样品浓缩干燥。分装后一份待检测,其余冷冻备用。
三、寄标本时需注明以下情况:
1、标本编号;2、所测项目;3、是否做复孔;3、联系方式;4、实验后标本是否寄回。
客户须知:
客户应对所提供的材料及信息负责,如因客户提供的材料及信息不准确而引起的实验延误或经济损失由客户承担。
上海酶联生物抗体常见问题汇总
1. 收到抗体产品后应如何处理
收到抗体后,在分装储存及使用时需在生物安全柜中进行,并使用无菌枪头、离心管、注射器和缓冲液等,降低污染率。另外,使用前抗体要处于低温状态。
2. 如何正确保存抗体抗体产品
请将抗体置于4℃避光储存。无菌操作。即使分装后,也不推荐将抗体冷冻保存。避免将抗体稀释至工作浓度后在4℃条件下储存超过一天,建议现用现配。
3. 如果没按说明书上的储存要求,将抗体置于室温储存了一段时间,还可以继续使用
一般来说,室温下放置几个小时不会影响抗体的活性,但是放置几天或者更长时间则有可能会导致蛋白降解,影响抗体活性,不建议使用。
4. 抗体抗体的保质期有多久
按说明书要求储存,抗体抗体有效期为1年。
5. 抗体抗体是冻干粉还是液体形式
抗体抗体均以无菌PBS缓冲液的形式提供。该溶液中不含稳定剂、防腐剂、载体蛋白、甘油或任何其他添加剂。抗体的pI值决定了PBS缓冲液的pH值。
6. 抗体收到后有漂浮物、絮状沉淀或聚集物是否正常?应如何处理
存在聚集物或沉淀物属于正常现象,不会影响抗体的活性。可以在室温下轻轻摇晃使其溶解,或过滤或离心去除。
7. 抗体抗体的浓度是多少
抗体不同批次抗体的浓度不同,但一般来说是在4到11mg/mL之间。包装的离心管上会标记抗体的具体浓度。如果需要在订购之前知道产品的确切浓度,如果不能确定可以先联系我们。
8. 应如何稀释抗体至工作浓度
在没有InVivoPure稀释缓冲液的情况下,可以使用与抗体PBS缓冲液pH相同或相近的的无菌PBS,以避免蛋白聚集。稀释时,建议使用预冷缓冲液,并在生物安全柜中操作,使用无菌枪头、试管、注射器和缓冲液来保持抗体的无菌性。应避免将抗体稀释至工作浓度后在4℃条件下储存超过一天。
9. 抗体抗体的氨基酸或DNA序列是什么
我们的抗体是使用标准杂交瘤技术生产的,因此抗体的AA或DNA序列通常是未知的。
10. 抗体抗体的抗原表位是什么
抗体不提供抗原表位信息,请客户咨询上海酶联生物。
11. 抗体抗体在体内的半衰期是多久
厂家内部并没有抗体在体内的半衰期数据。因为抗体的半衰期是高度可变的,并且受到物种、同型、抗原分布、抗原浓度和许多其他因素的影响。参考与您实验条件及设计相近的实验数据,预估抗体的半衰期。
12. 抗体抗体是否适用于体内注射实验
抗体所有的产品都是专门为体内使用而配制的。所有抗体均在无菌 InVivoPure缓冲液中配制。抗体溶液不含稳定剂、防腐剂、载体蛋白、甘油或任何其他添加剂。内毒素水平 <2EU/mg ( InVivoMab),这使它们有资格进行大多数体内研究。为了满足最严格的要求,抗体还提供内毒素水平较低的抗体:<1EU/mg ( InVivoPlus)。
13. 抗体抗体是否适合体外应用
可用于体外应用,例如细胞培养实验和诊断测定,包括蛋白质印迹、免疫沉淀、IHC、流式细胞术等。请参阅各个产品页面以获取已批准的列表每种抗体的应用。另外所有抗体抗体都是未偶联的,因此流式细胞术和免疫荧光等应用需要使用荧光染料偶联的二抗。
14. 小老鼠体内注射实验,应该多久注射一次?每次注射多少抗体
任何给定实验和抗体的最佳给药剂量和频率可能会因实验系统(即小鼠品系、疾病模型等)、实验持续时间、靶组织、抗原浓度和许多其他因素而有很大差异细节。出于这个原因,最佳剂量最好通过阅读与您感兴趣的抗体相关的产品参考文献来确定,以查找与您的实验系统类似的实验系统中的已发布数据。以此现有研究为起点,您可以通过实验优化给药剂量和频率。抗体的每种产品在产品网页上都有最新的参考列表。
15. 体内实验中同种型对照组是否重要?如何选择合适的同种型对照
考虑同型对照处理组需要生成可靠的数据,因为它允许研究人员准确地区分以抗原特异性方式从初级抗体结合观察到的结果和从非抗原特异性结合或抗体注射的其他非特异性作用观察到的结果。同型对照抗体必须与一抗的宿主物种、同种型和亚类相匹配。为了方便我们的客户,我们在每个产品页面上列出了每种抗体的推荐的同型对照货号。
16. 如果觉得自己的抗体效果不佳,怎么办
如果您怀疑您的抗体没有发挥最佳功能,请务必认真填写并提交技术服务申请表。您填写的实验信息越充分,抗体技术团队的建议才更可靠。